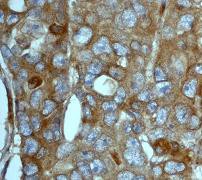

> Antigen, Antibodies, ELISA, Western Blot > Primary Antibody > Monoclonal Antibodies > Tuberin AntibodyBrand |
Leading Biology | Catalog Number |
APR10610G |
Product Type |
Monoclonal Antibodies | Field of Research |
|
Product Overview |
We constantly strive to ensure we provide our customers with the best antibodies. As a result of this work we offer this antibody in purified format.
We are in the process of updating our datasheets. If you have any questions regarding this update, please feel free to contact our technical support team.
This product is a high quality Tuberin antibody.
|
||
Molecular Weight |
200608 Da
|
||
Cellular Localization |
Antigen Cellular Localization:
Cytoplasm. Membrane; Peripheral membrane protein. Note=At steady state found in association with membranes
|
||
Host |
Rabbit
|
||
Species Reactivity |
Human
|
||
Target |
A synthetic peptide corresponding to residues of human Tuberin was used as an immunogen.
|
||
Clone |
EP1107Y
|
||
Symbol |
TSC4
|
||
GeneID |
|||
UniProt ID |
|||
Function |
In complex with TSC1, inhibits the nutrient-mediated or growth factor-stimulated phosphorylation of S6K1 and EIF4EBP1 by negatively regulating mTORC1 signaling. Acts as a GTPase- activating protein (GAP) for the small GTPase RHEB, a direct activator of the protein kinase activity of mTORC1. Implicated as a tumor suppressor. Involved in microtubule-mediated protein transport, but this seems to be due to unregulated mTOR signaling. Stimulates weakly the intrinsic GTPase activity of the Ras-related proteins RAP1A and RAB5 in vitro. Mutations in TSC2 lead to constitutive activation of RAP1A in tumors.
|
||
Summary |
Tuberous sclerosis complex-2 (TSC2 also known as Tuberin) is a tumor suppressor that forms a complex with TSC1 (Hamartin ) and this complex is known to control various cellular functions including cell cycle, endocytosis, adhesion, and transcription (1). The C-terminal region of TSC2 contains a GTPase-activating protein (GAP) domain which interacts with Rap1, Rab5 and Rheb (2). The TSC1/TSC2 complex inhibits phosphorylation of S6kinase and 4E-BP1 through inactivation of mTOR (3). Additionally, binding of 14-3-3 beta to TSC2 at Ser1210 reduce the ability of the complex to inhibit phosphorylation of S6 kinase (4). Phosphorylation by ATK at Ser924 and Thr1518 inactivates TSC2 and disrupts its interaction with TSC1 (5). Tuberous sclerosis (TSC), an autosomal dominant disorder that affects 1 in 6000 individuals, is caused by a mutation in either the TSC1 or TSC2 tumor suppressor gene.
|
||
Form |
50 mM Tris-Glycine (pH 7.4), 0.15 M NaCl, 40% Glycerol, 0.01% sodium azide and 0.05% BSA. |
||
Storage & Stability |
Store at +4°C short term. For long-term storage, aliquot and store at -20°C or below. Stable for 12 months at -20°C. Avoid repeated freeze-thaw cycles.
|
||
Applications |
WB, IHC
|
||
Dilution |
WB~~1:10000~20000
IHC~~1:100~250
|
||
Synonyms |
Tuberin, Tuberous sclerosis 2 protein, TSC2, TSC4
|
||
Images |

A. Western blot analysis on SH-SY5Y cell lysate using anti-Tuberin RabMAb (Cat. APR10610G), at 1:100,000 dilution.
B. Immunohistochemical analysis of paraffin-embedded human adenocarcinoma of uterus using anti-Tuberin RabMAb (1824-1) |
||
Specification |
|||
Quantity |
|
||
| Select | Brand | Catalog No. | Product Name | Pack Size | Type | Field of Research | Specification | Quantity | Price(USD) | |
| 1 | Leading Biology | APG02467G | CCK4 / PTK7 Antibody (clone 4F9) | 50 μl | Monoclonal Antibodies |
|
$495.00 | Add Ask | ||
| 2 | Leading Biology | AMM04683G | GALT Antibody (clone 4C11) | 50 μg | Monoclonal Antibodies |
|
$545.00 | Add Ask | ||
| 3 | Leading Biology | AMM01402G | Vimentin (Mesenchymal Cell Marker) Antibody - With BSA and Azide | 50 ug | Monoclonal Antibodies |
|
$395.00 | Add Ask | ||
| 4 | Leading Biology | APR08280G | LTA4H / LTA4 Antibody (clone 9G8) | 50 μl | Monoclonal Antibodies |
|
$495.00 | Add Ask | ||
| 5 | Leading Biology | AMM00172G | CD1a / HTA1 (Mature Langerhans Cells Marker) Antibody - With BSA and Azide | 50 ug | Monoclonal Antibodies |
|
$395.00 | Add Ask | ||
| 6 | Leading Biology | AMM05750G | CEBPA Antibody | 100 μl | Monoclonal Antibodies |
|
$545.00 | Add Ask |
 Leading Biology Inc.
2600 Hilltop DR, Building G, B Suite C138
Richmond, CA, 94806
Tel: 1-661-524(LBI)-0262
Email: info@leadingbiology.com
Leading Biology Inc.
2600 Hilltop DR, Building G, B Suite C138
Richmond, CA, 94806
Tel: 1-661-524(LBI)-0262
Email: info@leadingbiology.com
Complete this form and click send to ask us a question, request a quote or simply say hello.

You have 0 item in your cart

You have 0 item in your inquiry list
